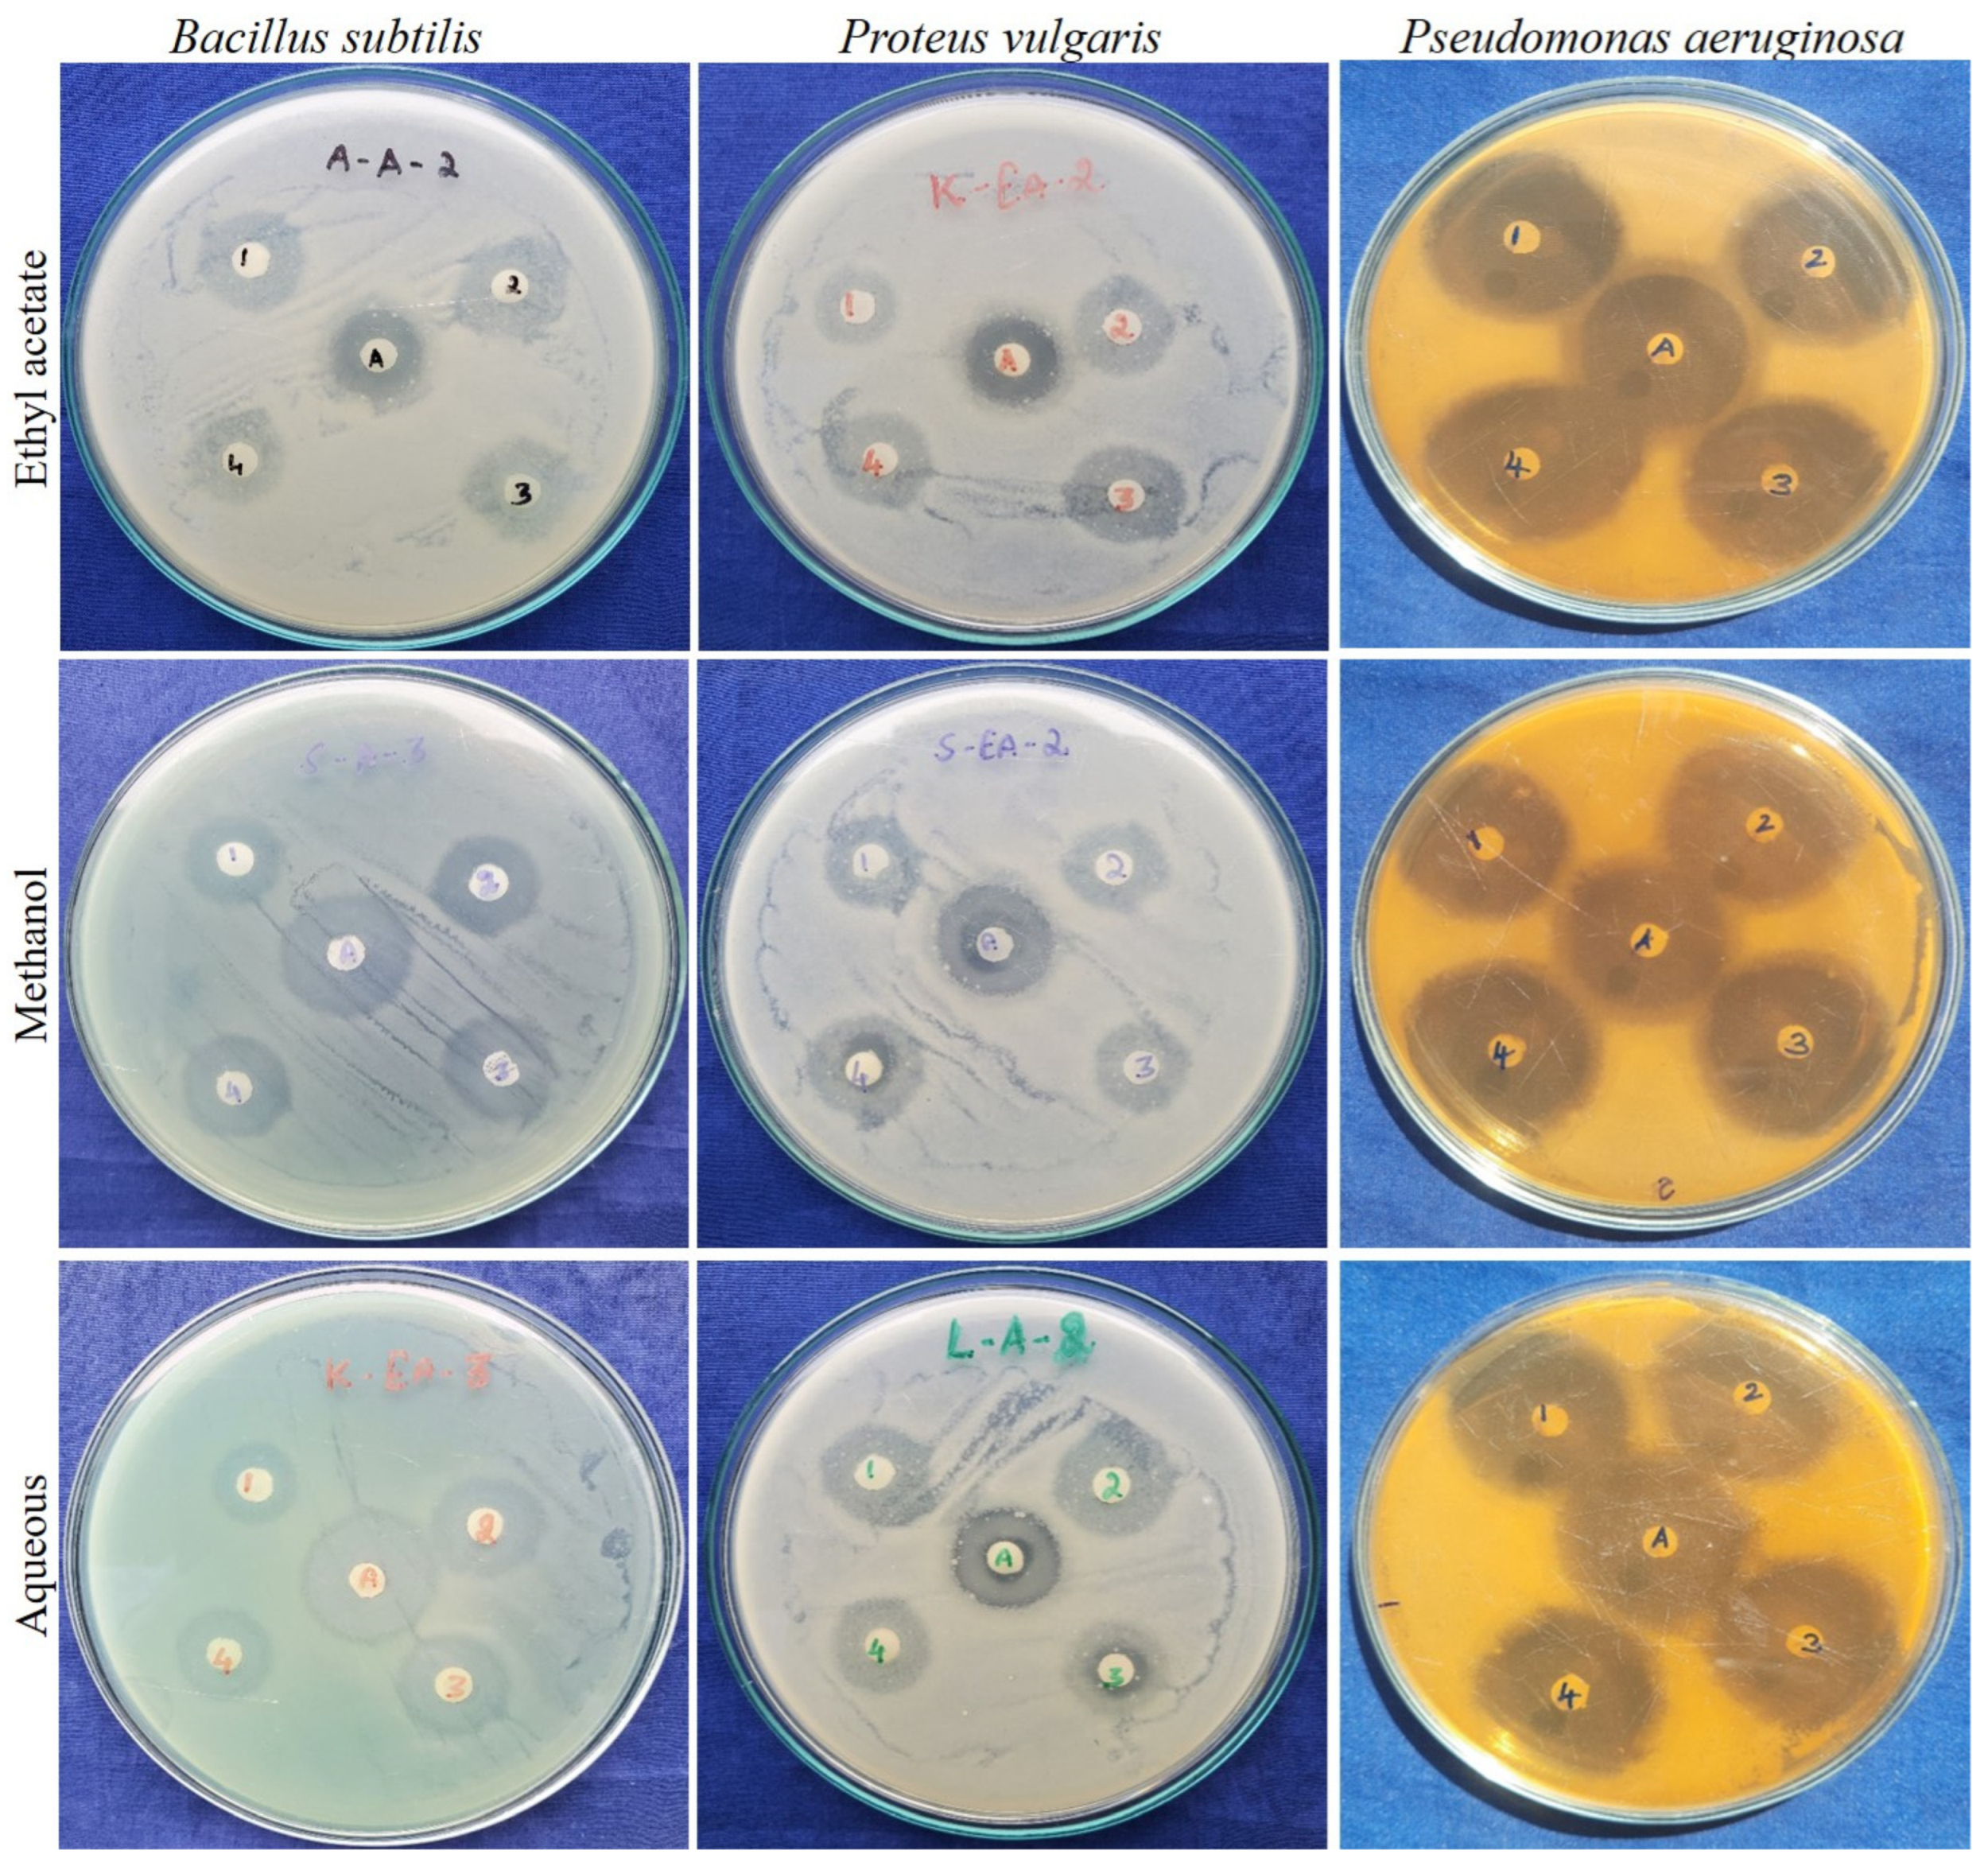
Pharmaceuticals 16 01636 g005

Nutritional Composition, Mineral Profiling, In Vitro Antioxidant, Antibacterial and Enzyme Inhibitory Properties of Selected Indian Guava Cultivars Leaf Extract
Abstract
:1. Introduction
2. Results and Discussion
2.1. Mineral Profiling and Nutritional Value of the Leaf Extracts of Guava Cultivars
2.2. In Vitro Biological Studies of Guava Leaf Extracts
2.2.1. Enzyme Inhibitory Effects of the Guava Cultivars
2.2.2. Free Radical Scavenging Potential of Guava Cultivars
2.2.3. Antibacterial Activity of Guava Leaf Cultivars
2.3. Correlation between the Quantitatively Analyzed Phytochemicals and Biological Assays
2.4. Principal Component Analysis (PCA)
3. Materials and Methods
3.1. Collection and Preparation of Guava Leaf Extracts
3.2. Nutritional Profiling
3.2.1. Elemental Analysis
3.2.2. Proximate Analysis
3.3. Free Radical Scavenging Activity of Guava Leaf Extracts
3.3.1. DPPH Radical Scavenging Assay
3.3.2. ABTS Radical Cation Decolorization Assay
3.3.3. Superoxide Radical Scavenging Activity
3.4. Enzyme Inhibitory Activity of Guava Leaf Extracts
3.4.1. α-Amylase Enzyme Inhibitory Assay
3.4.2. α-Glucosidase Enzyme Inhibitory Assay
3.4.3. Tyrosinase Enzyme Inhibitory Assay
3.5. Antibacterial Activity Leaf Extracts
3.5.1. Zone of Inhibition (ZOI) by Disc Diffusion Method
3.5.2. Determination of Minimum Inhibitory Concentration (MIC) by the Microdilution Method
3.6. Statistical Analysis
4. Conclusions
Author Contributions
Funding
Institutional Review Board Statement
Informed Consent Statement
Data Availability Statement
Acknowledgments
Conflicts of Interest
References
- Kumar, M.; Tomar, M.; Amarowicz, R.; Saurabh, V.; Nair, M.S.; Maheshwari, C.; Sasi, M.; Prajapati, U.; Hasan, M.; Singh, S.; et al. Guava (Psidium guajava L.) Leaves: Nutritional composition, phytochemical profile, and health-promoting bioactivities. Foods 2021, 10, 752. [Google Scholar] [CrossRef] [PubMed]
- Singh, S.P.; Mehta, S.K.; Singh, Y.T. New insight into the pigmented rice of northeast India revealed high antioxidant and mineral compositions for better human health. Heliyon 2022, 8, e10464. [Google Scholar] [CrossRef] [PubMed]
- Joehnke, M.S.; Jeske, S.; Ispiryan, L.; Zannini, E.; Arendt, E.K.; Bez, J.; Sørensen, J.C.; Petersen, I.L. Nutritional and anti-nutritional properties of lentil (Lens culinaris) protein isolates prepared by pilot-scale processing. Food Chem. X 2021, 9, 100112. [Google Scholar] [CrossRef]
- Biswas, B.; Rogers, K.; McLaughlin, F.; Daniels, D.; Yadav, A. Antimicrobial activities of leaf extracts of guava (Psidium guajava L.) on two gram-negative and gram-positive bacteria. Int. J. Microbiol. 2013, 13, 746165. [Google Scholar]
- Jamieson, S.; Wallace, C.E.; Das, N.; Bhattacharyya, P.; Bishayee, A. Guava (Psidium guajava L.): A glorious plant with cancer preventive and therapeutic potential. Crit. Rev. Food Sci. Nutr. 2021, 25, 192–223. [Google Scholar] [CrossRef]
- Daswani, P.G.; Gholkar, M.S.; Birdi, T.J. Psidium guajava: A single plant for multiple health problems of rural Indian population. Phcog Rev. 2017, 11, 167–174. [Google Scholar] [PubMed]
- Chatterjee, S.; Ghosh, S.; Mandal, N.C. Potential of an endophytic fungus Alternaria tenuissima PE2 isolated from Psidium guajava L. for the production of bioactive compounds. S. Afr. J. Bot. 2022, 150, 658–670. [Google Scholar] [CrossRef]
- Raj, M.S.A.; Santhi, V.P.; Amalraj, S.; Murugan, R.; Gangapriya, P.; Pragadheesh, V.S.; Sundaresan, V.; Gurav, S.S.; Paramaguru, P.; Arulmozhian, R.; et al. A comparative analysis of leaf essential oil profile, in vitro biological properties and in silico studies of four Indian Guava (Psidium guajava L.) cultivars, a promising source of functional food. S. Afr. J. Bot. 2023, 153, 357–369. [Google Scholar] [CrossRef]
- Denny, C.; Melo, P.S.; Franchin, M.; Massarioli, A.P.; Bergamaschi, K.B.; de Alencar, S.M.; Rosalen, P.L. Guava pomace: A new source of anti-inflammatory and analgesic bioactives. BMC Complement. Altern. Med. 2013, 13, 235. [Google Scholar] [CrossRef]
- Tella, T.; Masola, B.; Mukaratirwa, S. Anti-diabetic potential of Psidium guajava leaf in streptozotocin induced diabetic rats. Phytomed. Plus 2022, 2, 100254. [Google Scholar] [CrossRef]
- David, M.; Abraham, T.J.; Nagesh, T.S.; Adikesavalu, H. Immunomodulatory effect of Guavarine®, aqueous guava leaf extract, on ornamental Koi carp Cyprinus carpio var. koi L. 1758. J. Appl. Aquac. 2017, 29, 322–330. [Google Scholar]
- Lee, D.U.; Weon, K.Y.; Nam, D.Y.; Nam, J.H.; Kim, W.K. Skin protective effect of guava leaves against UV-induced melanogenesis via inhibition of ORAI1 channel and tyrosinase activity. Exp. Dermatol. 2016, 25, 977–982. [Google Scholar] [CrossRef]
- Singh, S.; Chidrawar, V.R.; Hermawan, D.; Dodiya, R.; Samee, W.; Ontong, J.C.; Ushir, Y.; Prajapati, B.; Chittasupho, C. Hypromellose highly swellable composite fortified with Psidium guajava leaf phenolic-rich extract for antioxidative, antibacterial, anti-inflammatory, anti-melanogenesis, and hemostasis applications. J. Polym. Environ. 2023, 31, 3197–3214. [Google Scholar] [CrossRef]
- de Assis Braga, D.C.; Gomes, P.M.; Batista, M.A.C.; de Souza, J.A.; Bastos, J.C.S.A.; Rodrigues-das-Dôres, R.G.; Alzamora, A.C.; de Souza, G.H.B.; de Moura, S.A.L.; Talvani, A.; et al. Effects of Psidium guajava L. leaves extract on blood pressure control and IL-10 production in salt-dependent hypertensive rats. Biomed. Pharmacother. 2022, 155, 113796. [Google Scholar]
- Lok, B.; Sandai, D.; Baharetha, H.M.; Nazari, V.M.; Asif, M.; Tan, C.S.; Majid, A.A. Anticancer effect of Psidium guajava (Guava) leaf extracts against colorectal cancer through inhibition of angiogenesis. Asian Pac. J. Trop. Biomed. 2020, 10, 293–307. [Google Scholar]
- Tousif, M.I.; Nazir, M.; Saleem, M.; Tauseef, S.; Shafiq, N.; Hassan, L.; Hussian, H.; Montesano, D.; Naviglio, D.; Zengin, G.; et al. Psidium guajava L. An Incalculable but underexplored food crop: Its phytochemistry, ethnopharmacology, and Industrial applications. Molecules 2022, 27, 7016. [Google Scholar] [CrossRef] [PubMed]
- Gutiérrez-Grijalva, E.P.; Picos-Salas, M.A.; Leyva-López, N.; Criollo-Mendoza, M.S.; Vazquez-Olivo, G.; Heredia, J.B. Flavonoids and phenolic acids from oregano: Occurrence, biological activity and health benefits. Plants 2017, 7, 2. [Google Scholar] [CrossRef] [PubMed]
- Shaheena, S.; Chintagunta, A.D.; Dirisala, V.R.; Sampath Kumar, N.S. Extraction of bioactive compounds from Psidium guajava and their application in dentistry. AMB Exp. 2019, 9, 208. [Google Scholar] [CrossRef] [PubMed]
- de Araújo Medeiros, K.; de Carvalho Moreira, L.M.C.; Reis, M.Y.D.F.A.; de Moura Pires, E.A.; da Rocha, W.R.V.; de Lima Damasceno, B.P.G.; da Silva, J.A.; Silva, D.T.C.; Beltrão, D.M.; de Souza Fernandes, M.M.M. Therapeutical potential of Psidium guajava L. (guava tree) for the development of pharmaceutical products. Res. Soc. Dev. 2023, 12, e7312139161. [Google Scholar] [CrossRef]
- Takeda, L.N.; Laurindo, L.F.; Guiguer, E.L.; Bishayee, A.; Araújo, A.C.; Ubeda, L.C.C.; Goulart, R.D.A.; Barbalho, S.M. Psidium guajava L.: A systematic review of the multifaceted health benefits and economic importance. Food Rev. Int. 2023, 39, 4333–4363. [Google Scholar] [CrossRef]
- Ojewole, J.A. Hypoglycaemic and hypotensive effects of Psidium guajava Linn. (Myrtaceae) leaf aqueous extract. Methods Find. Exp. Clin. Pharmacol. 2005, 27, 689–695. [Google Scholar] [CrossRef] [PubMed]
- Cheng, F.C.; Shen, S.C.; Wu, J.S. Effect of guava (Psidium guajava L.) leaf extract on glucose uptake in rat hepatocytes. J. Food Sci. 2009, 74, 132–138. [Google Scholar] [CrossRef] [PubMed]
- Nguyen, P.-D.; Hérent, M.-F.; Le, T.-B.; Bui, T.-B.-H.; Bui, T.-B.-H.; Do, T.-T.-H.; Nguyen, T.-P.; Scippo, M.-L.; Kestemont, P.; Quetin-Leclercq, J. Isolation of quercetin-3-O-sulfate and quantification of major compounds from Psidium guajava L. from Vietnam. J. Food Compos. Anal. 2023, 115, 104928. [Google Scholar] [CrossRef]
- Chen, X.; Zang, Y.; Zhang, S.; Wu, H.; Ma, J.; Chen, X.; Li, C.; Zhang, D. Psidials L and M and Psipinene, three novel meroterpenoids with significant protective activity toward cisplatin-damaged HK2 cells from the leaves of Psidium guajava. Tetrahedron Lett. 2023, 124, 154575. [Google Scholar] [CrossRef]
- Sherif, A.E.; Amen, Y.; Wink, M.; Sobeh, M.; Abdelrahman, R.S.; Shawky, N.M. Psidium guajava L.: Chemical composition and protective effects of a leaf extract against ethanol-induced cardiotoxicity. S. Afr. J. Bot. 2023, 162, 334–341. [Google Scholar] [CrossRef]
- Rehan, M.; Ahmed-Farid, O.A.; Ibrahim, S.R.; Hassan, A.A.; Abdelrazek, A.M.; Khafaga, N.I.; Khattab, T.A. Green and sustainable encapsulation of Guava leaf extracts (Psidium guajava L.) into alginate/starch microcapsules for multifunctional finish over cotton gauze. ACS Sustain. Chem. Eng. 2019, 7, 18612–18623. [Google Scholar] [CrossRef]
- Jani, N.A.; Azizi, N.A.A.; Aminudin, N.I. Phytochemical screening and anti-oxidant activity of Psidium guajava. Malays. J. Anal. Sci. 2020, 24, 173–178. [Google Scholar]
- Dinesh, M.R.; Vasugi, C. Guava improvement in India and future needs. J. Hortl. Sci. 2010, 5, 94–108. [Google Scholar] [CrossRef]
- Thomas, L.A.T.; Anitha, T.; Lasyaja, A.B.; Suganya, M.; Gayathri, P.; Chithra, S. Biochemical and mineral analysis of the undervalued leaves-Psidium guajava L. Int. J. Adv. Sci. Res. 2017, 2, 16–21. [Google Scholar]
- Rehman, M.A.U.; Khan, I. Medicinal and pharmacological potential of Guava leaf powder, A Review. Int. J Nat. Med. Health Sci. 2022, 1. [Google Scholar] [CrossRef]
- Shabbir, H.; Kausar, T.; Noreen, S.; Rehman, H.U.; Hussain, A.; Huang, Q.; Gani, A.; Su, S.; Nawaz, A. In vivo screening and antidiabetic potential of polyphenol extracts from guava pulp, seeds and leaves. Animals 2020, 10, 1714. [Google Scholar] [CrossRef]
- Bhadkaria, A.; Srivastava, N.; Bhagyawant, S.S. A prospective of underutilized legume moth bean (Vigna aconitifolia (Jacq.) Marechàl): Phytochemical profiling, bioactive compounds and in vitro pharmacological studies. Food Biosci. 2021, 42, 101088. [Google Scholar] [CrossRef]
- Bakshi, A.; Sharma, N.; Nagpal, A.K. Comparative evaluation of in vitro antioxidant and antidiabetic potential of five ethnomedicinal plant species from Punjab, India. S. Afr. J. Bot. 2022, 150, 478–487. [Google Scholar] [CrossRef]
- Amalraj, S.; Krupa, J.; Sriramavaratharajan, V.; Mariyammal, V.; Murugan, R.; Ayyanar, M. Chemical characterization, antioxidant, antibacterial and enzyme inhibitory properties of Canthium coromandelicum, a valuable source for bioactive compounds. J. Pharm. Biomed. Anal. 2021, 192, 113620. [Google Scholar] [CrossRef] [PubMed]
- Krupa, J.; Murugan, R.; Gangapriya, P.; Amalraj, S.; Gurav, S.; Sam Arulraj, M.; Ayyanar, M. Moringa concanensis Nimmo. seed extracts as a potential source of bioactive molecules, antioxidants and enzyme inhibitors. J. Food Meas. Charact. 2022, 16, 3699–3711. [Google Scholar] [CrossRef]
- Mazumder, M.A.R.; Tolaema, A.; Chaikhemarat, P.; Rawdkuen, S. Antioxidant and anti-cytotoxicity effect of phenolic extracts from Psidium guajava Linn. leaves by novel assisted extraction techniques. Foods 2023, 12, 2336. [Google Scholar] [CrossRef] [PubMed]
- Ugbogu, E.A.; Emmanuel, O.; Uche, M.E.; Dike, E.D.; Okoro, B.C.; Ibe, C.; Ude, V.C.; Ekweogu, C.N.; Ugbogu, O.C. The ethnobotanical, phytochemistry and pharmacological activities of Psidium guajava L. Arab. J Chem. 2022, 15, 103759. [Google Scholar] [CrossRef]
- Beidokhti, M.N.; Eid, H.M.; Villavicencio, M.L.; Jäger, A.K.; Lobbens, E.S.; Rasoanaivo, P.R.; McNair, L.M.; Haddad, P.S.; Staerk, D. Evaluation of the antidiabetic potential of Psidium guajava L. (Myrtaceae) using assays for α-glucosidase, α-amylase, muscle glucose uptake, liver glucose production, and triglyceride accumulation in adipocytes. J. Ethnopharmacol. 2020, 257, 112877. [Google Scholar] [CrossRef]
- Zhu, X.; Ouyang, W.; Pan, C.; Gao, Z.; Han, Y.; Song, M.; Feng, K.; Xiao, H.; Cao, Y. Identification of a new benzophenone from Psidium guajava L. leaves and its antineoplastic effects on human colon cancer cells. Food Funct. 2020, 10, 4189–4198. [Google Scholar] [CrossRef]
- Díaz-de-Cerio, E.; Girón, F.; Pérez-Garrido, A.; Pereira, A.S.P.; Gabaldón-Hernández, J.A.; Verardo, V.; Segura Carretero, A.; Pérez-Sánchez, H. Fishing the targets of bioactive compounds from Psidium guajava L. leaves in the context of diabetes. Int. J. Mol. Sci. 2023, 24, 5761. [Google Scholar] [CrossRef] [PubMed]
- Suroowan, S.; Llorent-Martínez, E.J.; Zengin, G.; Buskaran, K.; Fakurazi, S.; Abdalla, A.N.; Khalid, A.; Le Van, B.; Mahomoodally, M.F. Unveiling the antioxidant, clinical enzyme inhibitory properties and cytotoxic potential of Tambourissa peltata Baker-An understudied endemic plant. Molecules 2023, 28, 599. [Google Scholar] [CrossRef]
- Jassal, K.; Kaushal, S. Phytochemical and antioxidant screening of guava (Psidium guajava) leaf essential oil. Agric. Res. J. 2019, 56, 528. [Google Scholar] [CrossRef]
- Dewage, D.D.D.H.; Karunaratne, S.H.S.; Rajapakse, C.S.K. Guava (Psidium guajava L.) leaves as a source of phytochemicals with antioxidant, antimicrobial and photoprotective properties for sunscreen formulations. In Proceedings of the International Conference on Applied and Pure Sciences; University of Kelaniya: Kelaniya, Sri Lanka, 2021; Volume 2, p. 59. [Google Scholar]
- Savadi, S.; Vazifedoost, M.; Didar, Z.; Nematshahi, M.M.; Jahed, E. Phytochemical analysis and antimicrobial/antioxidant activity of Cynodon dactylon (L.) Pers. rhizome methanolic extract. J. Food Qual. 2020, 2020, 5946541. [Google Scholar]
- Ruksiriwanich, W.; Khantham, C.; Muangsanguan, A.; Phimolsiripol, Y.; Barba, F.J.; Sringarm, K.; Rachtanapun, P.; Jantanasakulwong, K.; Jantrawut, P.; Chittasupho, C.; et al. Guava (Psidium guajava L.) leaf extract as bioactive substances for anti-androgen and antioxidant activities. Plants 2022, 11, 3514. [Google Scholar] [CrossRef] [PubMed]
- Purba, R.A.P.; Paengkoum, P. Farang (Psidium guajava L.) dried leaf extracts: Phytochemical profiles, antioxidant, anti-diabetic, and anti-hemolytic properties for ruminant health and production. Molecules 2022, 27, 8987. [Google Scholar] [CrossRef] [PubMed]
- Naili, M.; Errayes, A.; Alghazeer, R.; Mohammed, W.A.; Darwish, M. Evaluation of antimicrobial and antioxidant activities of Psidium guajava L growing in Libya. Int. J Adv. Biol. Biomed. Res. 2020, 8, 419–428. [Google Scholar]
- Almulaiky, Y.; Zeyadi, M.; Saleh, R.; Baothman, O.; Al-shawafi, W.; Al-Talhi, H. Assessment of antioxidant and antibacterial properties in two types of Yemeni guava cultivars. Biocatal. Agric. Biotechnol. 2018, 16, 90–97. [Google Scholar] [CrossRef]
- Pereira, G.A.; Chaves, D.S.d.A.; Silva, T.M.e.; Motta, R.E.d.A.; Silva, A.B.R.d.; Patricio, T.C.d.C.; Fernandes, A.J.B.; Coelho, S.d.M.d.O.; Ożarowski, M.; Cid, Y.P.; et al. Antimicrobial activity of Psidium guajava aqueous extract against sensitive and resistant bacterial strains. Microorganisms 2023, 11, 1784. [Google Scholar] [CrossRef]
- da Cruz, E.d.N.S.; Peixoto, L.d.S.; da Costa, J.S.; Mourão, R.H.V.; do Nascimento, W.M.O.; Maia, J.G.S.; Setzer, W.N.; da Silva, J.K.; Figueiredo, P.L.B. Seasonal variability of a caryophyllane chemotype essential oil of Eugenia patrisii Vahl occurring in the Brazilian Amazon. Molecules 2022, 27, 2417. [Google Scholar] [CrossRef]
- Yoon, J.; Kim, M. In vitro evaluation of antidiabetic, antidementia, and antioxidant activity of Artemisia capillaris fermented by Leuconostoc spp. LWT 2022, 172, 114163. [Google Scholar] [CrossRef]
- Žarković, L.D.; Mileski, K.S.; Matejić, J.S.; Gašić, U.M.; Rajčević, N.F.; Marin, P.D.; Džamić, A.M. Phytochemical characterisation, in vitro antioxidant and antidiabetic activity of Rosa arvensis Huds. extracts. Food Biosci. 2022, 50, 102125. [Google Scholar] [CrossRef]
- AOAC (Association of Official Analytical Chemist). Official Methods of Analysis of the Analytical Chemist International, 18th ed.; AOAC: Rockville, MD, USA, 2012. [Google Scholar]
- Parimelazhagan, T. Pharmacological Assays of Plant-Based Natural Products. In Progress in Drug Research; Rainsford, K.D., Ed.; Springer: Berlin/Heidelberg, Germany, 2016; Volume 71. [Google Scholar]
- Amalraj, S.; Mariyammal, V.; Murugan, R.; Gurav, S.S.; Krupa, J.; Ayyanar, M. Comparative evaluation on chemical composition, in vitro antioxidant, antidiabetic and antibacterial activities of various solvent extracts of Dregea volubilis leaves. S. Afr. J. Bot. 2021, 138, 115–123. [Google Scholar] [CrossRef]
- Gangapriya, P.; Arulraj, M.S.; Amalraj, S.; Murugan, R.; Ayyanar, M. Phytochemical composition, enzyme inhibitory potential, antioxidant and antibacterial activities of Pisonia grandis R. Br. (lettuce tree) leaves. J. Food Meas. Charact. 2022, 16, 2864–2874. [Google Scholar] [CrossRef]
- Angelis, A.; Mavros, P.; Nikolaou, P.E.; Mitakou, S.; Halabalaki, M.; Skaltsounis, L. Phytochemical analysis of olive flowers’ hydroalcoholic extract and in vitro evaluation of tyrosinase, elastase and collagenase inhibition activity. Fitoterapia 2020, 143, 104602. [Google Scholar] [CrossRef] [PubMed]
- Borah, A.; Paw, M.; Gogoi, R.; Loying, R.; Sarma, N.; Munda, S.; Pandey, S.K.; Lal, M. Chemical composition, antioxidant, anti-inflammatory, anti-microbial and in-vitro cytotoxic efficacy of essential oil of Curcuma caesia Roxb. leaves: An endangered medicinal plant of North East India. Ind. Crops Prod. 2019, 129, 448–454. [Google Scholar] [CrossRef]
- Asl, N.M.; Ahari, H.; Moghanjoghi, A.A.M.; Paidari, S. Assessment of nanochitosan packaging containing silver NPs on improving the shelf life of caviar (Acipenser persicus) and evaluation of nanoparticles migration. J. Food Meas. Charact. 2021, 15, 5078–5086. [Google Scholar] [CrossRef]

| Parameters | Allahabad Safeda | Surka Chitti | Karela | Lucknow-49 |
|---|---|---|---|---|
| Total nitrogen (mg/100 g) | 1730 ± 1.09 | 2800 ± 1.27 | 1450 ± 1.41 | 2350 ± 1.43 |
| Total phosphorus (mg/100 g) | 170 ± 0.54 | 160 ± 1.08 | 210 ± 1.09 | 320 ± 1.12 |
| Total potassium (mg/100 g) | 480 ± 0.67 | 1140 ± 1.16 | 700 ± 1.26 | 1070 ± 1.28 |
| Total sodium (mg/100 g) | 20 ± 0.4 | 14 ± 0.17 | 24 ± 0.04 | 16 ± 0.14 |
| Total calcium (mg/100 g) | 2560 ± 1.12 | 2720 ± 1.43 | 2720 ± 1.37 | 1440 ± 1.39 |
| Total magnesium (mg/100 g) | 1340 ± 1.38 | 860 ± 0.49 | 1440 ± 1.24 | 1150 ± 1.42 |
| Total iron (mg/100 g) | 51.6 ± 0.76 | 15.9 ± 0.81 | 22.5 ± 0.50 | 44.8 ± 0.19 |
| Total zinc (mg/100 g) | 0.46 ± 0.32 | 0.32 ± 0.11 | 0.48 ± 0.07 | 0.32 ± 0.07 |
| Total copper (mg/100 g) | 0.51 ± 0.09 | 0.368 ± 0.29 | 0.52 ± 0.81 | 0.667 ± 0.26 |
| Total boron (mg/100 g) | 4 ± 0.10 | 1 ± 0.03 | 3 ± 0.02 | 3 ± 0.04 |
| Cultivars | Extracts | Minimum Inhibitory Concentration (µg/mL) | ||
|---|---|---|---|---|
| Gram-Positive Bacteria | Gram-Negative Bacteria | |||
| B. subtilis | P. vulgaris | P. aeruginosa | ||
| Surka chitti | Ethyl acetate | 118.75 | 950 | 59.38 |
| Methanol | 237.5 | 950 | 118.75 | |
| Aqueous | 237.5 | 950 | 118.75 | |
| Standard | 15 | 0.23 | 0.05859 | |
| Allahabad safeda | Ethyl acetate | 237.5 | 475 | 14.84 |
| Methanol | 118.75 | 118.75 | 29.69 | |
| Aqueous | 475 | 118.75 | 0 | |
| Standard | 0.9375 | >60 | 0.11719 | |
| Karela | Ethyl acetate | 59.38 | 118.75 | 59.38 |
| Methanol | 118.75 | 118.75 | 59.38 | |
| Aqueous | 950 | 950 | 950 | |
| Standard | 0.9375 | >60 | 0.11719 | |
| Lucknow-49 | Ethyl acetate | 237.5 | 475 | 950 |
| Methanol | 3.71 | 475 | 59.38 | |
| Aqueous | >950 | 237.5 | 950 | |
| Standard | 15 | 0.23 | 0.05859 | |
Disclaimer/Publisher’s Note: The statements, opinions and data contained in all publications are solely those of the individual author(s) and contributor(s) and not of MDPI and/or the editor(s). MDPI and/or the editor(s) disclaim responsibility for any injury to people or property resulting from any ideas, methods, instructions or products referred to in the content. |
© 2023 by the authors. Licensee MDPI, Basel, Switzerland. This article is an open access article distributed under the terms and conditions of the Creative Commons Attribution (CC BY) license (https://creativecommons.org/licenses/by/4.0/).
Share and Cite
Sam Arul Raj, M.; Amalraj, S.; Alarifi, S.; Kalaskar, M.G.; Chikhale, R.; Santhi, V.P.; Gurav, S.; Ayyanar, M. Nutritional Composition, Mineral Profiling, In Vitro Antioxidant, Antibacterial and Enzyme Inhibitory Properties of Selected Indian Guava Cultivars Leaf Extract. Pharmaceuticals 2023, 16, 1636. https://doi.org/10.3390/ph16121636
Sam Arul Raj M, Amalraj S, Alarifi S, Kalaskar MG, Chikhale R, Santhi VP, Gurav S, Ayyanar M. Nutritional Composition, Mineral Profiling, In Vitro Antioxidant, Antibacterial and Enzyme Inhibitory Properties of Selected Indian Guava Cultivars Leaf Extract. Pharmaceuticals. 2023; 16(12):1636. https://doi.org/10.3390/ph16121636
Chicago/Turabian StyleSam Arul Raj, Moses, Singamoorthy Amalraj, Saud Alarifi, Mohan G. Kalaskar, Rupesh Chikhale, Veerasamy Pushparaj Santhi, Shailendra Gurav, and Muniappan Ayyanar. 2023. "Nutritional Composition, Mineral Profiling, In Vitro Antioxidant, Antibacterial and Enzyme Inhibitory Properties of Selected Indian Guava Cultivars Leaf Extract" Pharmaceuticals 16, no. 12: 1636. https://doi.org/10.3390/ph16121636
APA StyleSam Arul Raj, M., Amalraj, S., Alarifi, S., Kalaskar, M. G., Chikhale, R., Santhi, V. P., Gurav, S., & Ayyanar, M. (2023). Nutritional Composition, Mineral Profiling, In Vitro Antioxidant, Antibacterial and Enzyme Inhibitory Properties of Selected Indian Guava Cultivars Leaf Extract. Pharmaceuticals, 16(12), 1636. https://doi.org/10.3390/ph16121636








